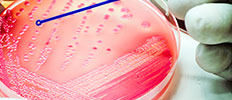

Industry Trends
- Sgs s.a. (29)
- EUROFINS SCIENTIFIC SE (29)
- Intertek Group plc (29)
- Als limited (25)
- PROMEGA CORPORATION (22)
- MICROBAC LABORATORIES, INC (19)
- Bureau veritas s.a. (19)
- MERIEUX NUTRISCIENCES CORPORATION (19)
- ASUREQUALITY LIMITED (18)
- TUV SUD AG (17)
Practices › Food safety & TIC
Food safety & TIC

Most Promising Segments “Food safety & TIC”
-
 Food Traceability Market
Food Traceability Market
According to MarketsandMarkets, the food traceability market size is projected to reach USD 26.1 billion by 2025, recording a CAGR of 9.1% during the forecasting period. This report includes a s ...
-
 Packaging Testing Market
Packaging Testing Market
The packaging testing market, in terms of value, is projected to reach USD 14.64 Billion by 2022, at a CAGR of 12.0% from 2017. This report includes a study of marketing and development strategie ...
-
 Biocompatible Coatings Market
Biocompatible Coatings Market
The biocompatible coatings market is expected to grow from USD 14.6 billion in 2022 to USD 29.7 billion by 2028, at a CAGR of 12.4% during the forecast period. Major players operating in the glob ...
-
 Dietary Supplements Testing Market
Dietary Supplements Testing Market
The dietary supplements testing market is estimated at USD 2,400.0 million in 2025 and is projected to reach USD 3,652.2 million by 2030, at a CAGR of 8.8%. The report profiles key players such a ...
-
 Rapid Food Safety Testing Market
Rapid Food Safety Testing Market
The rapid food safety testing market is projected to expand from USD 19.66 billion in 2025 to USD 31.22 billion by 2030, at a CAGR of 9.7% during the forecast period. The report profiles key play ...
-
 Environmental DNA Market
Environmental DNA Market
The environmental DNA market is projected to reach USD 5.61 billion by 2031, from USD 1.63 billion in 2026, with a CAGR of 10.2%. The report profiles key players such as Thermo Fisher Scientific ...
High Impact Segment
-
 Food Traceability Market
Food Traceability Market
According to MarketsandMarkets, the food traceability market size is projected to reach USD 26.1 billion by 2025, recording a CAGR of 9.1% during the forecasting period. This report includes a s ...
-
 Food Safety Testing Market
Food Safety Testing Market
The Food safety testing market is projected to reach USD 31.1 billion by 2027, at a CAGR of 8.1% during the forecast period. The key players in this market include SGS SA (Switzerland), Eurofins ...
-
 Top 10 Food Safety Testing and Technologies Trends Market
Top 10 Food Safety Testing and Technologies Trends Market
Markets and Markets: The food safety testing market is projected to reach to reach USD 33.7 billion by 2028, at a CAGR of 8.2% during the forecast period. This report includes a study of the mar ...
-
Bacteriological Testing Market
Bacteriological Testing Market
The bacteriological testing market is estimated to be valued at USD 25.83 billion in 2025. It is projected to reach USD 37.26 billion by 2030 at a CAGR of 7.6%. The bacteriological testing equipm ...
-
 Biocompatible Coatings Market
Biocompatible Coatings Market
The biocompatible coatings market is expected to grow from USD 14.6 billion in 2022 to USD 29.7 billion by 2028, at a CAGR of 12.4% during the forecast period. Major players operating in the glob ...
-
 Rapid Food Safety Testing Market
Rapid Food Safety Testing Market
The rapid food safety testing market is projected to expand from USD 19.66 billion in 2025 to USD 31.22 billion by 2030, at a CAGR of 9.7% during the forecast period. The report profiles key play ...
Company
- Sgs s.a.
- EUROFINS SCIENTIFIC SE
- Intertek Group plc
- Als limited
- PROMEGA CORPORATION
- MICROBAC LABORATORIES, INC
- Bureau veritas s.a.
- MERIEUX NUTRISCIENCES CORPORATION
- ASUREQUALITY LIMITED
- TUV SUD AG


